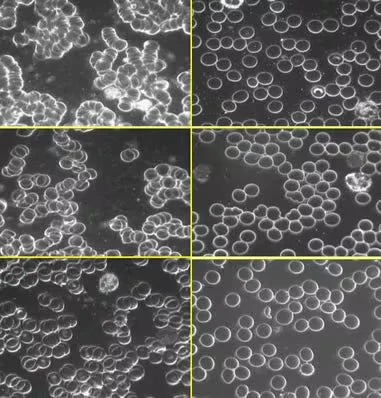

Maadoitus – Kehosi on suunniteltu olemaan jatkuvassa yhteydessä maahan
Mitä on maadoitus?
Maadoittuminen, tunnetaan myös nimellä grounding, tarkoittaa kehon yhdistämistä suoraan maan pinnan hienovaraiseen, luonnolliseen sähköenergiaan. Tämä yhteys voidaan saavuttaa esimerkiksi kävelemällä paljain jaloin ulkona tai käyttämällä erityisiä maadoitustuotteita, kuten maadoituslakanaa.

Miten maadoitus vaikuttaa kehoon?
Kun kehomme on yhteydessä maahan, se alkaa vastaanottaa maan negatiivisia ioneja. Nämä ionit tasapainottavat kehomme sähköistä varautumista, vähentävät vapaiden radikaalien määrää, parantavat unenlaatua, vähentävät stressiä ja tukevat yleistä hyvinvointia.

Mistä maa saa "virtaa" ja miten se "latautuu"?
Maa saa sähkövirtaa monista luonnollisista prosesseista, mukaan lukien salamoista. Kun salama iskee maahan, se vapauttaa valtavan määrän sähköenergiaa, joka varastoituu maaperään. Tämä luonnollinen prosessi auttaa pitämään maan pinnan negatiivisesti varautuneena. Lisäksi maan oma magneettikenttä ja aurinkotuuli ylläpitävät tätä sähkövarastoa jatkuvasti.

Tutkimukset maadoituksen vaikutuksista
Maadoitus on ollut useiden tieteellisten tutkimusten kohteena viime vuosikymmeninä. Näissä tutkimuksissa on havaittu, että maadoittuminen auttaa vähentämään tulehdusta, parantamaan unenlaatua, vähentämään kroonista kipua ja tasapainottamaan kehon stressitasoja. Tutkimukset ovat osoittaneet uskomattomia tuloksia, jotka tukevat maadoituksen hyötyjä kehon ja mielen hyvinvoinnille.
Nykyaikaisen elämän vaikutus
Kautta historian ihmiset kävelivät, istuivat ja nukkuivat maassa, viljelivät maataan paljain käsin ja viettivät suuren osan ajastaan luonnollisesti maassa. Nykyään olemme kuitenkin yhä enemmän irtautuneet luonnosta nykyaikaisen elämäntapamme vuoksi. Nykyään elämme korkeissa rakennuksissa, käytämme kumi- ja muovipohjaisia kenkiä, ja meitä ympäröivät eristävät materiaalit, kuten muovit, synteettiset kankaat, terva ja asfaltti, jotka kaikki erottavat meidät maapallon energiasta ja estävät tämän luonnollisen yhteyden.
Maadoituksen vaikutus uneen
Maadoitus unen aikana antaa keholle useita tunteja vapaita elektroneja aikana, jolloin kehossa tapahtuu eniten paranemista ja uusiutumista.
Maadoituksen unen aikana on myös osoitettu säätelevän kehon luonnollista vuorokausirytmiä, joka tunnetaan myös uni-valveilujaksona, mikä johtaa lukuisiin mahdollisiin terveyshyötyihin, mukaan lukien; parantunut unen laatu, syvempi ja palauttavampi uni, helpompi nukahtaminen, selkeys heräämisen jälkeen, unettomuuden väheneminen ja paljon muuta.
Seuraavissa kuvissa näkyy 44-vuotias nainen, jolla on krooninen selkäkipu. Lääketieteessä yleisesti käytetyllä kuvantamismenetelmällä termografialla tarkkailtuna vasen kuva on otettu ennen maadoitusta. Punaiset kuviot edustavat "kuumia" kivun ja tulehduksen alueita. Oikeassa kuvassa näkyy jyrkkä tulehduksen väheneminen neljän yön maadoittuneen nukkumisen jälkeen.

Tutkimukset maadoituksen vaikutuksista uneen:
2.Maadoituksen vaikutukset meditaation laatuun: Alustava tutkimusraportti 2019 (tiivistelmä)














NatureDream™ | Maadoituslakana
Koe maassa virtaavan energian hyödyt kotonasi. NatureDream™ ei ole vain lakana, vaan olennainen työkalu optimaaliseen hyvinvointiin, jolla yhdistät itsesi maan luonnolliseen ja parantavaan energiaan.
Maadoituksen vaikutus verenkiertoon
Alla oleva kaavio osoittaa maadoituksen vaikutukset punasoluihin.
Tutkimuksessa maadoituksella osoitettiin olevan luonnollinen veren ohennusvaikutus vähentämällä veren viskositeettia (paksuutta) ja irrottamalla punasolut.
Punasolujen pinnalla on negatiivinen sähkövaraus, joka ylläpitää solujen etäisyyttä. Mitä vahvempi negatiivinen varaus, sitä suurempi on solujen kyky torjua toisiaan ja sitä parempi veren viskositeetti on.
Maadoitus lisää luonnollisesti negatiivista varausta, mikä antaa punasoluille mahdollisuuden torjua toisiaan tehokkaammin ja estää niitä kasaantumasta yhteen.
Tuloksena on parantunut verenkierto, lisääntynyt verenkierto ja vahvempi immuunitoiminta. Verenvirtauksella on keskeinen rooli ihmisten terveydelle, koska veren tehtävänä on kuljettaa happea, ravinteita ja jätteitä kehossa. Veri kuljettaa myös valkosoluja ja tappaja-T-soluja, jotka auttavat estämään infektioita ja toksisuutta.
Tällaisten tutkimusten tulokset ovat lisä todisteita siitä, että ihmiskeho on suunniteltu olemaan säännöllisesti yhteydessä maapalloon ja että säännöllinen maadoitus saattaa olla jopa tarpeellista pitämään keho terveenä ja hyvässä kunnossa.

Laserkontrastikamera, joka näyttää merkittävän kasvojen verenkierron parantumisen puolen tunnin kuluessa maadoituksesta.
Tutkimuksia maadoituksen vaikutuksista verenkiertoon:
Maadoituksen vaikutus kroonisiin kipuihin
Maadoitus auttaa lievittämään kroonisia kipuja useiden mekanismien kautta. Se normalisoi stressihormoni kortisolin tasoja, mikä vähentää tulehdusta ja kipua. Lisäksi maadoitus vähentää oksidatiivista stressiä, koska kehoon siirtyvät vapaat elektronit toimivat antioksidantteina, neutraloiden vapaita radikaaleja ja vähentäen tulehdusperäistä kipua. Parantunut verenkierto ja vähentynyt veren viskositeetti auttavat kuljettamaan happea ja ravinteita tehokkaammin kudoksiin, mikä nopeuttaa toipumista ja vähentää lihas- ja nivelkipuja. Näiden vaikutusten ansiosta maadoitus on tehokas ja luonnollinen menetelmä kroonisten kipujen ja muiden kiputilojen hallintaan.
Tutkimuksia maadoituksen vaikutuksista kroonisiin kipuihin:
2.Maadoitus – yleinen tulhdusta ehkäisevä lääke
Alhaalta löydät lisää maadoituksesta tehtyjä tutkimuksia:
- Kuinka paikallinen maadoitus yhdistettynä johtavaan ihonhoitoon parantaa perinteisen ihonhoidon tuloksia? 2021
- Maadoituksen vaikutukset kehontyöntekijöiden kipuun ja yleiseen elämänlaatuun: satunnaistettu kontrolloitu tutkimus 2019
- Hypertensiopotilaiden maadoittaminen parantaa verenpainetta: Tapaushistoria-sarjatutkimus 2018
- Maadoituksen vaikutukset kehon jännitteeseen ja virtaan sähkömagneettisten kenttien läsnä ollessa 2016
- Alkalisen ruokavalion ja veden terveysvaikutukset, ruoansulatuskanavan bakteerikuormituksen vähentäminen ja maadoitus 2016
- Ihmiskehon maadoituksen vaikutus mielialaan 2015
- Kokeellinen tutkimus suoran avojaloin kosketuksen välittömästä vaikutuksesta maapallon prehypertensioon 2015
- Ihmisen organismin maadoitus vaikuttaa biosähköisiin prosesseihin 2012
- Pilottitutkimus maadoituksen vaikutuksesta viivästyneeseen lihaskipuun 2010
- Maadoituksen vaikutus ihmisen fysiologiaan, osa 2 2007
- Maadoituksen vaikutus ihmisen fysiologiaan, osa 1 2006

